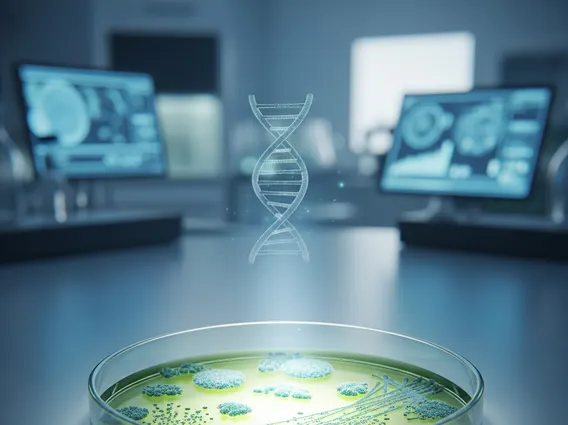
In Situ

Idiopathic Pneumonia Syndrome
Idiopathic Pneumonia Syndrome (IPS) is a severe and often life-threatening lung complication characterized by widespread lung injury without an identifiable infectious cause. It primarily affects individuals with compromised immune systems, particularly those undergoing intensive medical treatments.

Key Takeaways
- Idiopathic Pneumonia Syndrome is a serious lung condition with no known infectious cause.
- It most commonly affects patients who have undergone hematopoietic stem cell transplantation.
- Symptoms include rapid onset of shortness of breath, cough, and fever, indicating severe lung inflammation.
- Diagnosis involves ruling out infections and other known causes of lung injury.
- Treatment focuses on supportive care and immunosuppressive medications, primarily corticosteroids.
What is Idiopathic Pneumonia Syndrome?
Idiopathic Pneumonia Syndrome refers to a non-infectious lung injury that develops in individuals, most notably in recipients of hematopoietic stem cell transplantation (HSCT). The term “idiopathic” signifies that the exact cause remains unknown, distinguishing it from pneumonia caused by bacteria, viruses, or fungi. This syndrome is characterized by diffuse alveolar damage, meaning widespread inflammation and injury to the tiny air sacs (alveoli) in the lungs. It represents a significant cause of morbidity and mortality in vulnerable patient populations, often presenting as acute respiratory distress syndrome (ARDS).
The development of IPS is believed to be a complex interplay of various factors, including conditioning regimens used before transplantation, graft-versus-host disease, and other immune dysregulations, rather than a single identifiable trigger. Its diagnosis requires a thorough exclusion of all potential infectious agents and other known causes of lung injury, making it a diagnosis of exclusion.
Idiopathic Pneumonia Syndrome: Symptoms and Causes Explained
The presentation of idiopathic pneumonia syndrome symptoms typically involves a rapid onset of respiratory distress. These symptoms can progress quickly, necessitating urgent medical intervention. Recognizing these signs early is crucial for timely management. Common symptoms include:
- Progressive shortness of breath (dyspnea)
- Persistent dry cough
- Fever, often without a clear source
- Hypoxemia (low oxygen levels in the blood)
- Chest discomfort or pain
- Rapid breathing (tachypnea)
Regarding idiopathic pneumonia syndrome causes explained, while the precise etiology remains unknown, IPS is strongly associated with certain medical contexts. The most prominent risk factor is hematopoietic stem cell transplantation (HSCT), where it can occur within the first 100 days post-transplant. Factors contributing to its development in this setting include the high-dose chemotherapy and radiation used in conditioning regimens, which can directly damage lung tissue. Additionally, immune dysregulation, such as that seen in graft-versus-host disease (GVHD), is thought to play a role in the pathogenesis of IPS. Other potential contributing factors might include certain medications, pre-existing lung conditions, or viral reactivations that do not directly cause pneumonia but prime the lung for injury.
Treatment Options for Idiopathic Pneumonia Syndrome
Managing idiopathic pneumonia syndrome treatment options is challenging due to its non-infectious and idiopathic nature. The primary goals of treatment are to reduce lung inflammation, provide respiratory support, and manage underlying conditions. Treatment typically involves a multi-faceted approach:
High-dose corticosteroids are the cornerstone of therapy, aimed at suppressing the inflammatory response in the lungs. These medications, such as methylprednisolone, are often administered intravenously and tapered gradually based on the patient’s response. While corticosteroids can be effective in some cases, their use is associated with potential side effects, especially in immunocompromised patients.
Supportive care is critical and includes:
- Oxygen Therapy: To maintain adequate blood oxygen levels, ranging from nasal cannulas to mechanical ventilation for severe respiratory failure.
- Fluid Management: Careful monitoring of fluid balance to avoid exacerbating lung edema.
- Infection Control: Despite IPS being non-infectious, patients are highly susceptible to secondary infections, so broad-spectrum antibiotics or antifungals may be used empirically while awaiting culture results to rule out co-existing infections.
In cases where corticosteroids alone are insufficient, other immunosuppressive agents may be considered, although evidence for their efficacy in IPS is less robust. These might include agents like mycophenolate mofetil or tacrolimus, particularly if there is an underlying component of graft-versus-host disease. The prognosis for IPS can be severe, with mortality rates varying depending on the underlying patient population and the severity of lung injury. Early diagnosis and aggressive treatment are essential to improve outcomes.